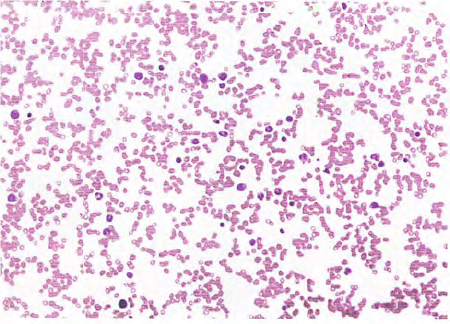
不能不知的骨髓涂片结果分析(上)

血细胞分析仪出现异常结果时做血涂片复检的必
1461x1999 - 1710KB - PNG

骨髓及外周血涂片结果出来了,请大神解读下
750x1334 - 64KB - JPEG

血液癌症。血涂片通常是用作后续测试结果异常
1500x1185 - 428KB - JPEG

血常规分析中的误差因素及血涂片复检规则__
1080x720 - 35KB - JPEG

五分类血液分析仪与血涂片镜检对白血病患者及
2376x3365 - 69KB - PNG

血涂片复检规则及应用资料.ppt
1152x864 - 54KB - PNG

一例蜱虫叮咬的病例分析|狗狗常见病-波奇网百
315x235 - 38KB - JPEG

外周血涂片和骨髓涂片是诊断血液病的两大利剑
746x324 - 75KB - PNG

血涂片详细解析 之 红细胞 - 临检 - 中华检验医
359x240 - 15KB - JPEG

血涂片分析在血常规检验中的应用价值.doc
794x1123 - 48KB - PNG

血液癌症。血涂片通常是用作后续测试结果异常
450x345 - 39KB - JPEG
不能不知的骨髓涂片结果分析(上)
450x324 - 298KB - PNG

血涂片详细解析 之 红细胞 - 临检 - 中华检验医
395x252 - 11KB - JPEG

血细胞分析仪测定和读片分析--有核红细胞增加
640x480 - 91KB - JPEG

血涂片的制备实验
470x229 - 16KB - JPEG
血涂片是血液细胞学检查的基本方法,应用极广,特别是对各种血液病的诊断有很大血涂片的制作及血细胞观察
分析测试百科网的血涂片报告结果分析专题。自50 年代初库尔特先生发明了粒子计数技术的专利,制造了第一台
血涂片正常值是多少?关于血涂片的检查结果介绍和分析,血涂片临床意义介绍等等.
篇一:实验四血涂片形态检查 实验四血涂片形态检查 Examination 另外血涂片制作中未及时干燥固定也
病情分析:白细胞偏低,血涂片中见大量幼稚细胞,提示为血液病可能性大,须骨髓穿刺并提供详细的检查报告。
求问血涂片参考值,这个报告单怎么看 为您推荐: 你好,这个时候是不用担心的呢,自己这个时候还是要多注意
血涂片结果如何判断是否正常 问题分析:嗜中性杆状核粒细胞血细胞自动计数仪:(0.04~0.5)×109/L 嗜中性
《中国人血涂片市场分析报告(2012版)》立足于人血涂片市场发展现状分析,《中国人血涂片市场供需现状调查
血液分析仪检测的圆 标本进行结果并伴有 晕豫,月豫,酝豫其中一项增高明显,血涂片结果检出的异常率较高,